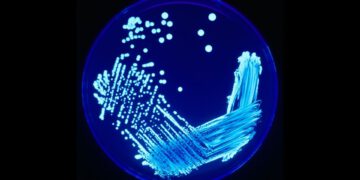
legionella

Aby zapewnić jak najlepsze wrażenia, korzystamy z technologii, takich jak pliki cookie, do przechowywania i/lub uzyskiwania dostępu do informacji o urządzeniu. Zgoda na te technologie pozwoli nam przetwarzać dane, takie jak zachowanie podczas przeglądania lub unikalne identyfikatory na tej stronie. Brak wyrażenia zgody lub wycofanie zgody może niekorzystnie wpłynąć na niektóre cechy i funkcje.
Przechowywanie lub dostęp do danych technicznych jest ściśle konieczny do uzasadnionego celu umożliwienia korzystania z konkretnej usługi wyraźnie żądanej przez subskrybenta lub użytkownika, lub wyłącznie w celu przeprowadzenia transmisji komunikatu przez sieć łączności elektronicznej.
Przechowywanie lub dostęp techniczny jest niezbędny do uzasadnionego celu przechowywania preferencji, o które nie prosi subskrybent lub użytkownik.
Przechowywanie techniczne lub dostęp, który jest używany wyłącznie do celów statystycznych.
Przechowywanie techniczne lub dostęp, który jest używany wyłącznie do anonimowych celów statystycznych. Bez wezwania do sądu, dobrowolnego podporządkowania się dostawcy usług internetowych lub dodatkowych zapisów od strony trzeciej, informacje przechowywane lub pobierane wyłącznie w tym celu zwykle nie mogą być wykorzystywane do identyfikacji użytkownika.
Przechowywanie lub dostęp techniczny jest wymagany do tworzenia profili użytkowników w celu wysyłania reklam lub śledzenia użytkownika na stronie internetowej lub na kilku stronach internetowych w podobnych celach marketingowych.